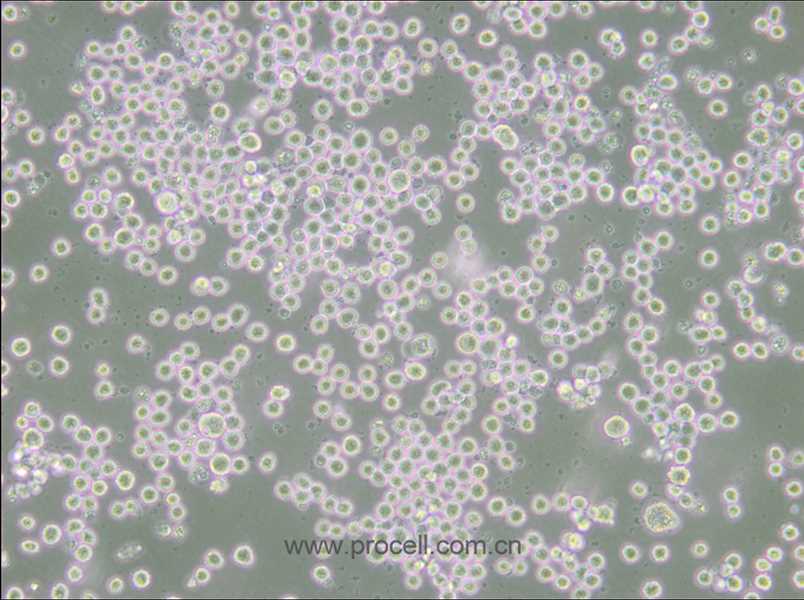
35.1(雜交瘤細(xì)胞抗CD2) (種屬鑒定正確)

產(chǎn)品中心Cell Resources
聯(lián)系我們CONTACT US
400-999-210024小時服務(wù)熱線
產(chǎn)品概述
| 名稱 | 35.1(雜交瘤細(xì)胞抗CD2) (種屬鑒定正確) |
| 種屬 | 小鼠 |
| 生長特性 | 懸浮細(xì)胞 |
| 細(xì)胞形態(tài) | 淋巴母細(xì)胞樣 |
| 凍存條件 | 凍存液:55% 基礎(chǔ)培養(yǎng)基+40%FBS+5%DMSO 溫度:液氮 |
| 培養(yǎng)方案A(默認(rèn)) |
培養(yǎng)條件:
氣相:空氣,95%;CO2,5%, 溫度:37℃
|
| 推薦傳代比例 | 3×10^5-5×10^5cells/mL |
| 推薦換液頻率 | 2-3次/周 |
| 注意事項(xiàng) | 該細(xì)胞為懸浮細(xì)胞,請注意離心收集細(xì)胞懸液;請勿直接倒掉細(xì)胞培養(yǎng)液。 |
| 背景描述 | 動物用佛波醇肉豆寇酸(PMA)活化的人T淋巴細(xì)胞免疫。脾細(xì)胞與P3/NS1/1-Ag4.1骨髓瘤細(xì)胞融合。 抗體與人T細(xì)胞表面蛋白Tp50(CD2)反應(yīng)。 抗體抑制T細(xì)胞增殖反應(yīng)和細(xì)胞毒反應(yīng),但不抑制抗體倡導(dǎo)的細(xì)胞毒反應(yīng)。 |
| 細(xì)胞類型 | 腫瘤細(xì)胞 |
| 腫瘤類型 | 雜交瘤細(xì)胞 |
STR鑒定
-
STR位點(diǎn)信息
18-3 18,19 6-7 12 5-5 13,14,15,16 X-1 25,26 1-2 16,17 7-1 25.2,26.2,28.2 8-1 13 1-1 15,16,17 19-2 13 15-3 22.3 12-1 16 6-4 18 4-2 21.3,22.3 3-2 13,14,15 2-1 15,16,17 13-1 15.2,16.2,17.2
11-2 17,18 17-2 15,16 -
STR鑒定圖
-
FAQs
Q:{{item.question}}
A:
產(chǎn)品資料
識別碼示意圖